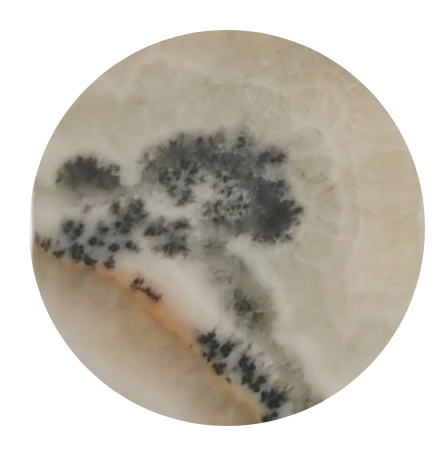
Gallery / Inkfall Over Quiet Hills

Gallery / Inkfall Over Quiet Hills
This refined dendritic agate cabochon has been expertly fashioned into a graceful cartouche shape, allowing the natural inclusions to unfold like a serene landscape. The lapidary has carefully oriented the stone to highlight a flowing composition, where soft brown and inky dendritic formations descend across a quiet, pale field—evoking the poetic image of an inkfall cascading over tranquil hills.
The cutting demonstrates a thoughtful balance between precision and artistic sensitivity, preserving the delicate dendritic structures while enhancing their visual narrative. Subtle tonal transitions and organic patterns create a sense of depth and gentle movement, as if the scene is slowly unfolding within the stone. The elongated cartouche form further accentuates this vertical flow, guiding the viewer’s eye through the composition with quiet elegance.
|
Stone: |
Dendritic Agate |
|
Mine: |
Unknown |
|
Weight: |
58.83 ct |
|
Size: |
43mm x 22mm x 5mm |
|
Shape: |
Cartouche |
|
Color: |
Creamy white |
|
Clarity: |
Opaque |
|
Treatment: |
Untreated |
|
Luster: |
Waxy |